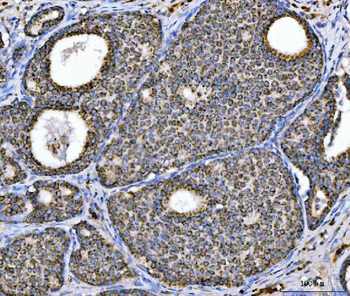
Aconitase 2 Mouse Monoclonal Antibody
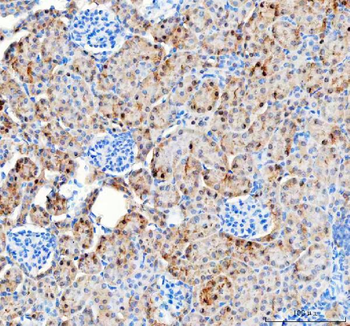
Pyruvate Carboxylase/PC Rabbit Polyclonal Antibody

You have no items in your shopping cart.
All Products
- CLASP1 Rabbit Polyclonal Antibody [orb1184727]
ELISA, IF, IHC, WB
Human, Rat
Rabbit
Polyclonal
Unconjugated
100 μg - Aconitase 2 Mouse Monoclonal Antibody [orb1184737]
IHC, WB
Human, Mouse, Rat
Mouse
Monoclonal
Unconjugated
100 μg FC, ICC, IF, IHC, IP, WB
Human, Mouse, Rat
Rabbit
Monoclonal
Unconjugated
100 μl- Goat Rabbit IgG (H+L) Secondary Antibody (Biotin) [orb1474935]
ELISA, IHC
Rabbit
Goat
Polyclonal
Biotin
0.5 ml, 1 ml - BCAT2 Rabbit Polyclonal Antibody [orb1819416]
ELISA, FC, IF, IHC, WB
Human, Mouse, Rat
Rabbit
Polyclonal
Unconjugated
100 μg - ATG7 Rabbit Polyclonal Antibody [orb1819451]
ELISA, FC, ICC, IF, IHC, WB
Human
Rabbit
Polyclonal
Unconjugated
100 μg - IDUA Rabbit Polyclonal Antibody [orb1819474]
ELISA, FC, IF, IHC, WB
Human, Mouse, Rat
Rabbit
Polyclonal
Unconjugated
100 μg - IDH3A Rabbit Polyclonal Antibody [orb1819478]
ELISA, FC, ICC, IF, IHC, WB
Human, Mouse, Rat
Rabbit
Polyclonal
Unconjugated
100 μg - Pyruvate Carboxylase/PC Rabbit Polyclonal Antibody [orb1819442]
ELISA, FC, ICC, IF, IHC, WB
Human, Mouse, Rat
Rabbit
Polyclonal
Unconjugated
100 μg - Aurora A/AURKA Rabbit Polyclonal Antibody [orb1290027]
ELISA, FC, IHC, WB
Human
Rabbit
Polyclonal
Unconjugated
100 μg